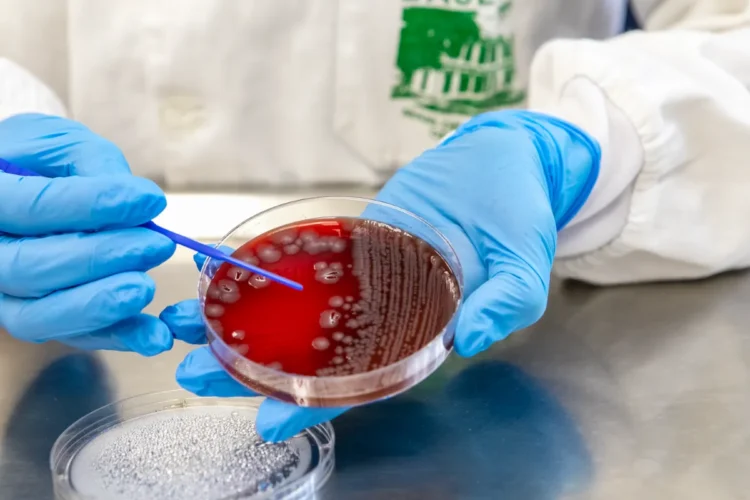

Verão com saúde: cuidados podem evitar a incidência de viroses
Sesa explica que maior preocupação é com as doenças diarreicas agudas
Com as temperaturas mais altas e a proximidade da temporada de verão, a Secretaria de Estado da Saúde (Sesa-PR) orienta a população sobre a incidência de viroses – os problemas que podem causar e cuidados para se proteger.
A maior preocupação é com as doenças diarreicas agudas (DDAs), cujos casos podem ser leves ou graves. A atenção deve ser redobrada com os idosos, crianças, gestantes e com pessoas que estejam com baixa imunidade. A doença é transmitida, principalmente, pela via fecal-oral, pelo consumo de água e alimentos contaminados, contato com objetos e pessoa a pessoa.
Segundo dados da Sesa, o Paraná registrou, em janeiro de 2025, 27 surtos de DDAs, um número considerado alto em comparação ao mesmo período do ano passado, com 5. Os surtos são identificados quando pelo menos duas pessoas apresentam sintomas de diarreia resultante do consumo do mesmo alimento ou água contaminada, com vínculo entre os doentes em um espaço geográfico determinado.
Além dos surtos, as Unidades Sentinelas de DDA Saúde registraram 12.198 casos na primeira semana epidemiológica de 2025. Número também maior do que o mesmo período de 2024, quando foram contabilizados 9.067.
“Os cuidados tomados pela população se somam aos esforços da Secretaria da Saúde para evitar doenças que possam se transformar em surtos. Quando nos deparamos com situações como essas, estamos prontos para o atendimento onde for. Mesmo assim, é essencial tomar os cuidados para evitar a doença”, disse o secretário de Estado da Saúde, Beto Preto.
De acordo com dados do Laboratório Central do Estado (Lacen), os exames apontaram que, em janeiro e fevereiro deste ano, o norovírus (vírus de alto contágio que causa condições gastrointestinais) foi responsável por 37% dos casos no Paraná.
Cuidados
As DDAs são caracterizadas por três episódios ou mais de diarreia em 24 horas e podem estar ou não associadas a outros sintomas, como náusea, vômito ou dor abdominal.
Paraná recebe primeiras vacinas contra o vírus sincicial respiratório para gestantes
Os sintomas podem durar entre 3 e 14 dias. Em caso de adoecimento, é preciso fazer a ingestão de bastante água para evitar desidratação, além de uma alimentação leve e balanceada para regular a flora intestinal. Os médicos lembram que fazer automedicação pode piorar os sintomas. O correto é buscar ajuda na unidade de saúde para avaliação médica caso os sintomas persistam.
Confira algumas ações que evitam as DDAs:
- Lavar sempre as mãos antes e depois de utilizar o banheiro, trocar fraldas, manipular/preparar os alimentos, amamentar, tocar em animais;
- Lavar e desinfetar as superfícies, utensílios e equipamentos usados na preparação de alimentos;
- Proteger os alimentos e as áreas da cozinha contra insetos, animais de estimação e outros animais (guardar os alimentos em recipientes fechados);
- Guardar a água tratada em vasilhas limpas e de boca estreita para evitar a recontaminação;
- Não utilizar água de riachos, rios, cacimbas ou poços contaminados;
- Ensacar e manter a tampa do lixo sempre fechada. Quando não houver coleta de lixo, este deve ser enterrado;
- Usar sempre o vaso sanitário, mas se isso não for possível, enterrar as fezes sempre longe dos cursos de água;
- Manter o aleitamento materno, que aumenta a resistência das crianças contra as diarreias, evitando o desmame precoce
